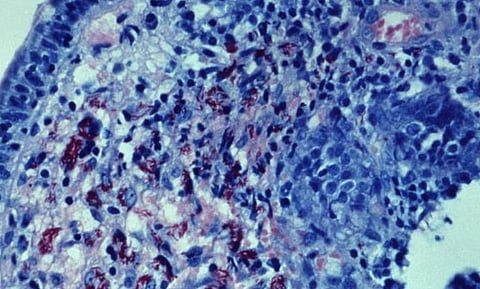
This photomicrograph of an acid-fast-stained small bowel tissue biopsy specimen. (IMAGE: CDC PHIL)

Don't let pain define you, let it refine you
~~ TIM FARGO
Cells that can expand and propagate in an uncontrolled manner would make a tumor or a neoplasm. Having a tumor doesn’t mean it has the capability of indefinite growth, and many times a tumor doesn’t invade the surrounding healthy tissues. This is said to be benign. A tumor may become dangerous when it starts to get aggressive and progress into the surrounding healthy tissues
This kind of behavior is called malignant. The process by which most malignant tumors spread is called metastasis, the clusters of cells break away from the original growth, then travels some distance and start propagating at the place where it gets stuck. The site of the original tumor growth is called the primary site, and the rest of the places where the dislodged cells get stuck are called secondary sites.
The cancers are classified according to their embryonic origin of the tissue:
Carcinomas – develop from epithelial origins like that of the gut, skin, or any lining of the glands and internal organs in the body. Some examples are Carcinoma breast, and carcinoma lung and carcinoma colon.
Sarcomas—these arise from mesodermal connective tissues, these tissues also give rise to bones, fats, and cartilage. They are rare and account for just 1% of cancers. Bone cancers are often seen among this category of cancers.
Lymphomas, Myelomas, and Leukemias—these are cancers that occur from the blood cells, the hematopoietic stem cells give rise to the mature blood cells and if any mutation of any damage to the DNA.
Lymphomas and Myelomas arise from the later stages of the development of the blood cell, it develops when the progenitor blood cells move out of the bone marrow and the cancer cells move into the circulation, they can also return to the bone marrow. Lymphomas are known to spread through the lymphatic system and then to the secondary organs of the lymphoid system. Swollen lymph nodes are the first symptom of these kinds of cancers.
Myelomas are characterized by the proliferation of Differentiated B cells (plasma cells), they produce antibodies that are mutated. These mutated antibodies are called M proteins. They take up residence and often cause anemia and pain in the bone. Much of the symptoms are bone lesions.
Common Human Infectious Carcinogens
Infectious Agent --- Type [RNA/DNA] --- Cancer
HTLV1 (HUMAN T CELL LEUKEMIA VIRUS 1) RNA TYPE ADULT T CELL LEUKEMIA OR LYMPHOMA.
HPV (HUMAN PAPILOMAVIRUS) DNA TYPE CERVICAL CANCER.
EBV(EPSTEIN-BARR VIRUS) DNA TYPE BURKITT’S LYMPHOMA AND NASOPHARYNGEAL CARCINOMA.
HHV-8 (HUMAN HERPES VIRUS-8) DNA TYPE KAPOSI’S SARCOMA.
HBV&HCV (HEPATITIS B AND C VIRUSES) DNA TYPE LIVER CARCINOMA.
MCV(MERKEL CELL POLYOMAVIRUS) DNA TYPE MERKEL CELL CARCINOMA (MCC).
Causes for Cancer
Idiopathic
Tobacco use
Tanning (excessive exposure to ultraviolet light)
Diet (red, processed meats)
Excessive Alcohol consumption
Unsafe sex (leading to viral infection)
Inflammatory conditions, such as ulcerative colitis or obesity
Excessive sun exposure (UV)
Chemical carcinogen exposure
High-dose chemotherapy and radiation (mainly in children being treated for existing cancers)
Hormonal drugs
Immune-suppressing drugs (taken by transplant recipients)
Radioactive materials, e.g., radon
Genes Associated With Cancer Control
Normally the body has a mechanism to control the growth of the cells and their proliferation in the tissues. The mechanism the body employs is cell death or apoptosis. The genes of the body involved in maintaining the status quo of the functioning of the homeostatic process are mainly growth-regulating genes. They can normally control and destroy those cells that demonstrate out-of-control growth in the body.
1. Tumor suppressor genes: these genes try and suppress uncontrolled growth of the cells.
Rb Suppressor of retinoblastoma
TP53 Nuclear phosphoprotein that inhibits formation of small-cell lung cancer and colon cancers
DCC Suppressor of colon carcinoma
APC Suppressor of adenomatous polyposis
NF1 Suppressor of neurofibromatosis
WT1 Suppressor of Wilms tumor
2. Genes regulating apoptosis or Programmed cell death [PCD]: these genes destroy and induce cell death in those that are mutated or have been damaged beyond repair.
Bcl-2 Suppressor of apoptosis
Bcl-x Suppressor of apoptosis
Bax Inducer of apoptosis
Bim Inducer of apoptosis
Puma Inducer of apoptosis
3. PROTO-ONCOGENES: the genes that help in the uncontrolled growth of the cells.
Sis A form of platelet-derived growth factor (PDGF)
Fms Receptor for colony-stimulating factor 1 (CSF-1)
Erbb Receptor for epidermal growth factor (EGF)
Neu Protein (HER2) related to EGF receptor
Erba Receptor for thyroid hormone
Src Tyrosine kinase
Abl Tyrosine kinase
Ha-ras GTP-binding protein with gtpase activity
N-ras GTP-binding protein with gtpase activity
K-ras GTP-binding protein with gtpase activity
Jun Component of transcription factor AP1
Fos Component of transcription factor AP1
Myc DNA-binding protein
The Cancer cell doesn’t become malignant overnight, it arises from small timid changes, one step at a time to achieve this rate of uncontrolled replication. It can be driven by somatic mutations; early genetic changes are very hard to detect. There are very few means to detect the early onset of a genetic mutation, i.e. if the genes do not show expression of a defective protein
These factors contribute to the critical initiation of malignancy. For example, If we take the adenoma, Normal epithelium may undergo loss of gene function, causing the epithelium to become a hyperproliferative epithelium, then activation of the K-ras gene or DNA hypomethylation may lead to early adenomas.
The K ras helps the proliferation and the next stage of cancer is intermediate adenoma. The loss of DCC gene function gives rise to late adenoma. Another important loss of gene function called TP53 gives rise to the actual carcinoma and then this gives rise to metastasis.
Enabling characteristics and hallmarks of cancer
Sustained proliferative signaling
Evading growth suppressors
Activating invasion and metastasis
Resisting cell death
Inducing Angiogenesis
Enabling Replicative Immortality
The Tumor Antigens
The body has markers and tumour-specific antigens or TSAs that we can assay to find out what kind of cancer we might be dealing with:
1. Viral TSAs
HPV: L1, E6,E7 Cervical carcinoma
HBV: HBsAg Hepatocellular carcinoma
SV40: Tag Malignant pleural mesothelioma (cancer of the lung lining)
2. Over- expressive TSAs
MUC1 Breast, ovarian
MUC13/CA Ovarian
125 Breast, melanoma, ovarian, gastric, pancreatic
HER-2/neu Melanoma
MAGE Prostate
PSMA Prostate, breast, ovarian
TPD52 Prostate
PSA Prostate
3. Differentiation stage TSAs
CEA Colon
gp100 Melanoma
AFP Hepatocellular carcinoma
Tyrosinase Melanoma
Cancer is When Immortality is Given to the Cells with a added Pinch of Greed
Dr. Kalyan Kumar Saha Roy , DTMH, Ex SR. Deputy Director, SAIL BGH
Some Cancer Prevention Tips
Avoid using tobacco or tobacco-containing products.
Have a healthy diet.
Maintaining a healthy weight and BMI.
Protection from UV radiation.
Get vaccinated against cancer, those that are available like cervical cancer vaccine.